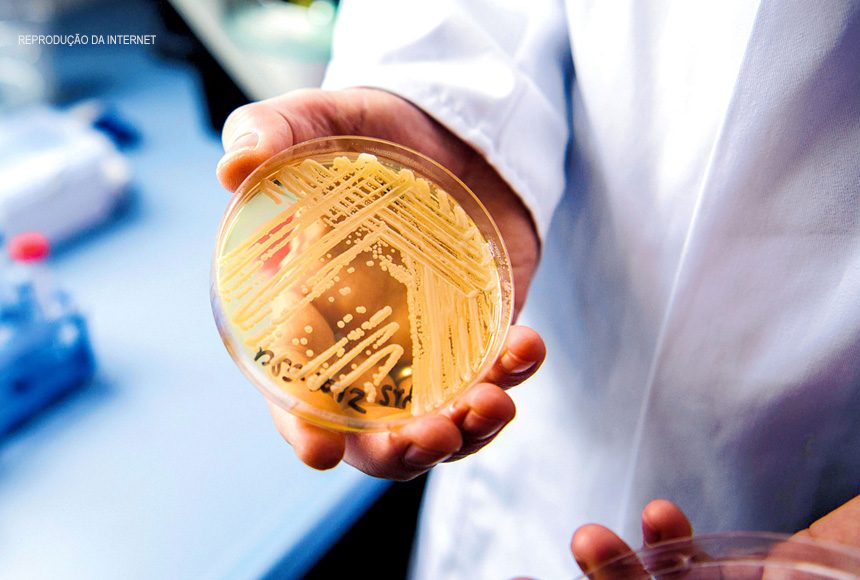

A Agência Nacional de Vigilância Sanitária (Anvisa) publicou hoje (8) uma nota de alerta sobre o diagnóstico de um caso de infecção por Candida auris (C. auris) em território brasileiro.
Segundo informa o boletim, o diagnóstico ocorreu em um adulto internado no estado da Bahia e foi confirmado pelo Laboratório do Hospital das Clínicas da Faculdade de Medicina da Universidade de São Paulo.
A Anvisa destaca que o fungo “representa uma grave ameaça à saúde global”, e que já havia emitido um alerta de risco anteriormente, em 2017. O alerta foi feito em função de relatos de surtos da doença causada pelo C. auris na América Latina comunicados pela Organização Pan-Americana da Saúde (Opas), da Organização Mundial da Saúde (OMS).
A Anvisa trabalha para revisar o comunicado de risco emitido anteriormente e informa que uma força-tarefa nacional já está organizada. “A Agência está trabalhando para contemplar a nova situação epidemiológica do país, a inclusão de outros laboratórios como referência para a rede nacional e as novas evidências científicas disponíveis. Recomendamos que os serviços de saúde e laboratórios de microbiologia estejam alertas às orientações”, registra a nota.
O alerta de risco sobre o fungo C. auris emitido pela Anvisa está disponível para o público.